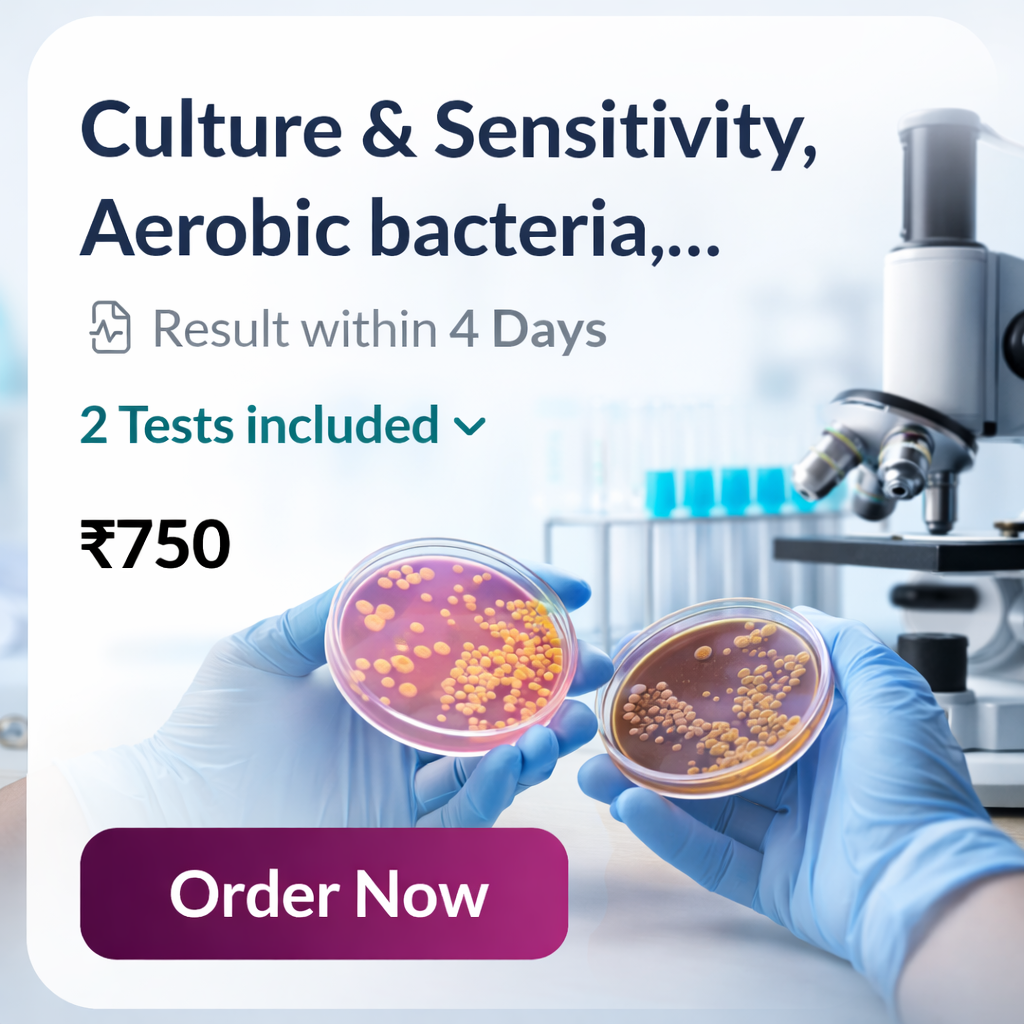
Culture & Sensitivity – Aerobic Bacteria (Urine)

Shop By Category
Hair Fact
Skin Fact
Find Your Match
Shop By Concern
Pro Fact
Lab Tests & Packages
Popular Checkups in Chennai
3 Steps to book a test!
Women Wellness Plan
For women, more than just routine checkups - it’s the care behind them that matters. LifeCell’s Womens Health Packages are tailored to support your unique health journey, particularly when it involves fertility planning, pregnancy, or navigating challenges such as miscarriage, genetic risks, or infections. Whether you're trying to conceive, undergoing IVF, or simply want to ensure your reproductive health is in check, these specialised health packages offer vital screenings and expert insights that truly matter.
Because your journey deserves more than guesswork, it deserves care backed by science and empathy.
Blog post
Testimonials
Booking the consultation was easy, and the doctor explained everything clearly. The products suggested for my hair fall and scalp issues are working really well. It feels reassuring to finally follow a routine backed by expert advice.

I never had time to visit a dermatologist, so Ourderma Store was perfect for me. The personalised skincare plan for my dull and uneven skin tone has genuinely improved my skin texture. It’s effective without being overwhelming.

I used to randomly buy skincare based on Instagram reels, which honestly made my skin worse. With Ourderma Store, I finally understood what suits my skin. The routine is simple and easy to follow, and my breakouts have reduced slowly but clearly.

I don’t have time to visit a clinic, so this worked well for me. The consultation was smooth, and the products suggested for my hair fall are helping gradually. It feels nice to follow something that makes sense.

I liked that the routine was not complicated. My skin looks more even now and feels healthier overall. I didn’t expect instant results, but after a few weeks I could clearly see a difference.